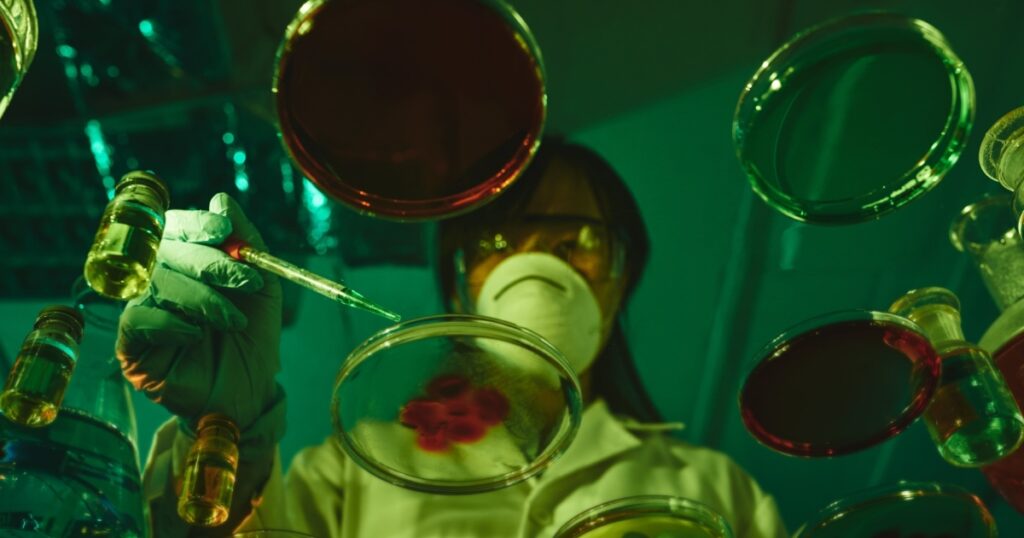

North Ireland hip-hop triad Kneecap still had a rebellion prior to showing up in Mo Chara court today and introduced a signboard requisition in London.
A collection of signboards were introduced on the company’s social networks in advance of Mo Chara’s arranged to show up in Westminster Crown Court on Wednesday.
Mo Chara, birthed in Liam Hornard, was billed last month by the London Metropolitan Authorities after sustaining purportedly sustaining militant teams Hamas and Hezbollah in historic video clips. Both are forbidden as terrorist companies under British legislation and criminal activities are taken into consideration under the Terrorism Act 2000.
In reaction, Kneecap asserted that the supposed criminal offense was just a “sidetracked circus” and was meant to change the emphasis to even more pertinent concerns. “We refute this ‘criminal offense’ and will highly safeguard ourselves,” Knikap created in a declaration.
The team’s prompt signboard activity coincided as their preliminary reaction, and social networks articles saw the team seeing the information that they had actually uploaded particularly in support for the upcoming court look, which they noted as “witch searching.”
” The British court has actually long implicated individuals in north Ireland of ‘terrorism’ of criminal activities that have actually never ever been dedicated,” they created. “We will certainly combat them. We will certainly win.”
The signboard (in the shades of the Irish flags of environment-friendly, white and orange) was “much more blacks, even more pet dogs, even more Irish, Mo Chala”, describing the motto “No Irish, No Irish, No Irish, No Irish, No Blacks, No Blacks, No Dogg” that obtained allure in the 20th century to victimize the above teams.
Presently, KNEECAP is additionally intending to execute at the Glastonbury Celebration in England later on this month, although political leaders throughout the UK have actually contacted celebration coordinators that have actually scheduled the band to inquire to eliminate them.
Although the team is still in the last lineup of Glastonbury, they lately drew from the TRNSMT Celebration in Scotland in July because of safety issues from police.